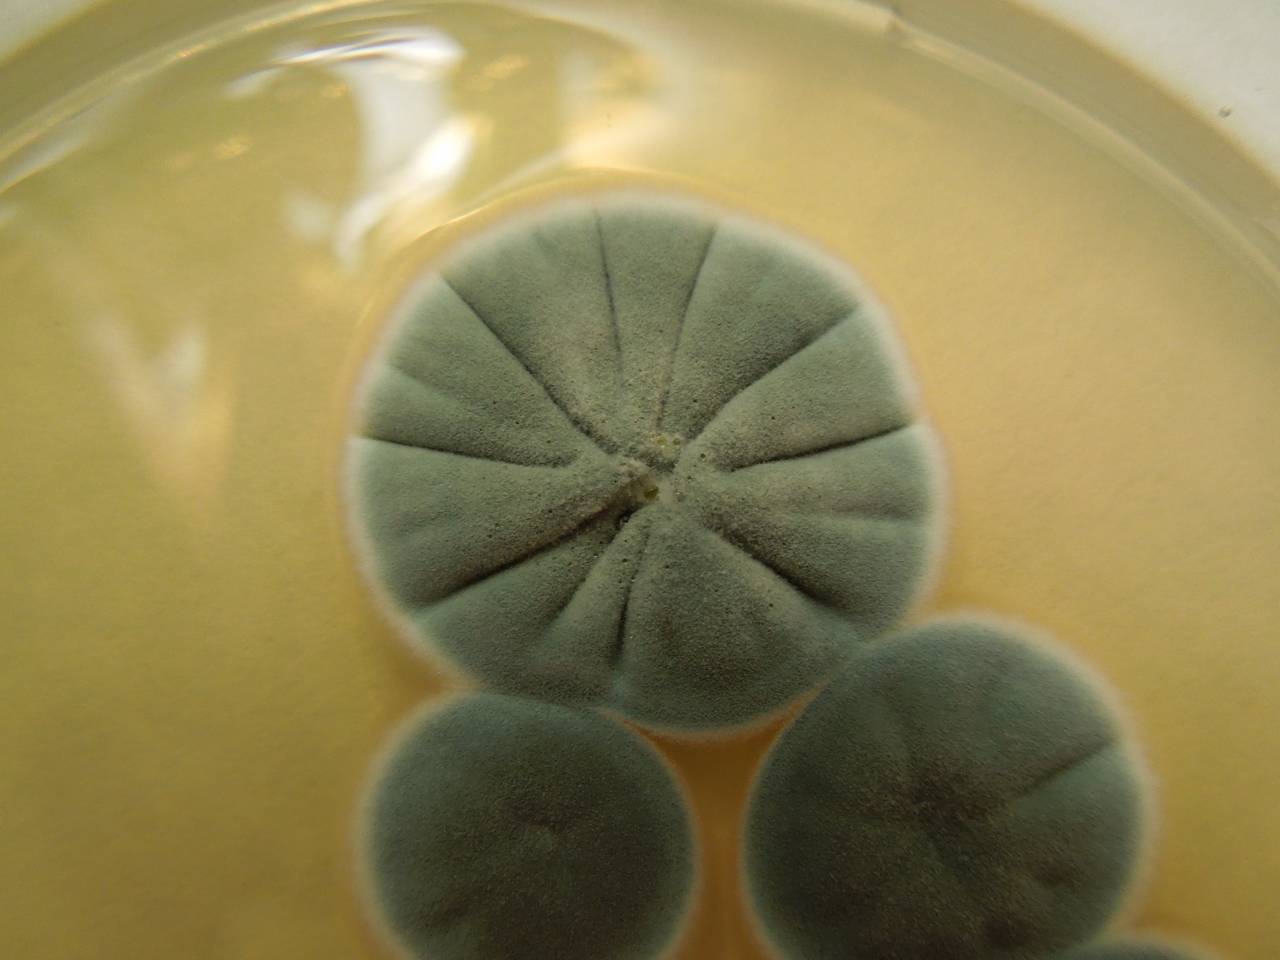

Грибы содержат в клетках хлорофилл
Грибы содержат в клетках хлорофилл 83 фото
Ssh handshake failed
Вог для начинающих
Картридж для насоса 58383
Атоми корейская бады
Примера p12 вариатор
Какая нитка нужна для вязания крючком
Культура и восприятие личности
Шланг тормозной 4310 гайка гайка
Почему тыква внутри зеленая
Устранение запаха содой